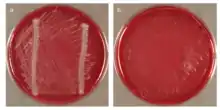

Chloroflexi
Taxonavigation
Prokaryota
Superregnum: Bacteria
Group: Terrabacteria group
Phylum: Chloroflexi
Classes: Anaerolineae – Ardenticatenia – Caldilineae – Chloroflexia – Dehalococcoidia – Ktedonobacteria – Thermoflexia – Thermomicrobia
Name
Chloroflexi
References
- Chloroflexi – Taxon details on National Center for Biotechnology Information (NCBI).
- European Nucleotide Archive
Vernacular names
English: green non-sulfur bacteria
中文: 绿弯菌门
中文: 绿弯菌门
This article is issued from Wikimedia. The text is licensed under Creative Commons - Attribution - Sharealike. Additional terms may apply for the media files.